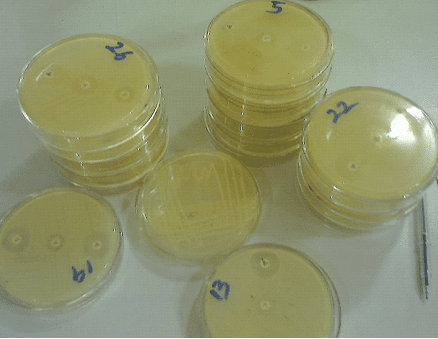

GENERAL PURPOSE MEDIA General purpose media or basic medium is a routine culture media which […]
Category: Culture media
Luria Broth (LB) and Luria Agar (LA) Media
Luria-Bertani (LB) broth is the most widely used medium for the growth of bacteria. It […]
CULTURE (GROWTH) MEDIA
The clinical diagnosis of some infectious diseases (including those caused by bacteria and fungi) in […]
INCUBATION & STERILIZATION TECHNIQUE
Microorganisms are incubated in the incubator at different temperatures and time interval depending on the […]
CULTURING TECHNIQUE
Culturing technique is used for the propagation of microorganisms in the microbiology laboratory; and it […]
Selenite F broth
In the microbiology laboratory, pure cultures of microorganisms (e.g., bacteria) are critical to the success […]
Chromatic Vancomycin Resistant Enterococci (VRE) agar
Chromatic VRE is a selective and differential chromogenic medium used for the qualitative and presumptive detection […]
Desoxycholate Citrate Agar (DCA)
Desoxycholate Citrate Agar (DCA) is a selective medium for the isolation of Salmonella and Shigella […]
Cetrimide selective agar
Cetrimide selective agar is used for the selective cultivation and isolation of Pseudomonas aeruginosa isolates from clinical […]
Calculation for preparing culture media
In this section, you will learn how to calculate for culture media preparation. Calculations for […]
BAIRD–PARKER AGAR
Baird–parker agar is a selective medium for the enumeration of Staphylococcus aureus in foods and […]
PETRI DISHES
Petri dishes are shallow glass or plastic plates that are cylindrical in shape, and which […]
Eugon LT SUP Medium
Eugon LT Sup is a nutritious (broth) medium for detecting and enumerating microorganisms in cosmetics. […]
Buffered Charcoal Yeast Extract (BCYE) Agar
Buffered Charcoal Yeast Extract (BCYE) Agar is used for primary isolation and cultivation of Legionella pneumophila […]
Chromogenic culture media for detecting antimicrobial resistance mechanisms
Chromatic Super CAZ/AVI Chromogenic medium for detecting Ceftazidime-avibactam resistant Gram-negative bacteria. Chromatic Super CAZ/AVI is […]